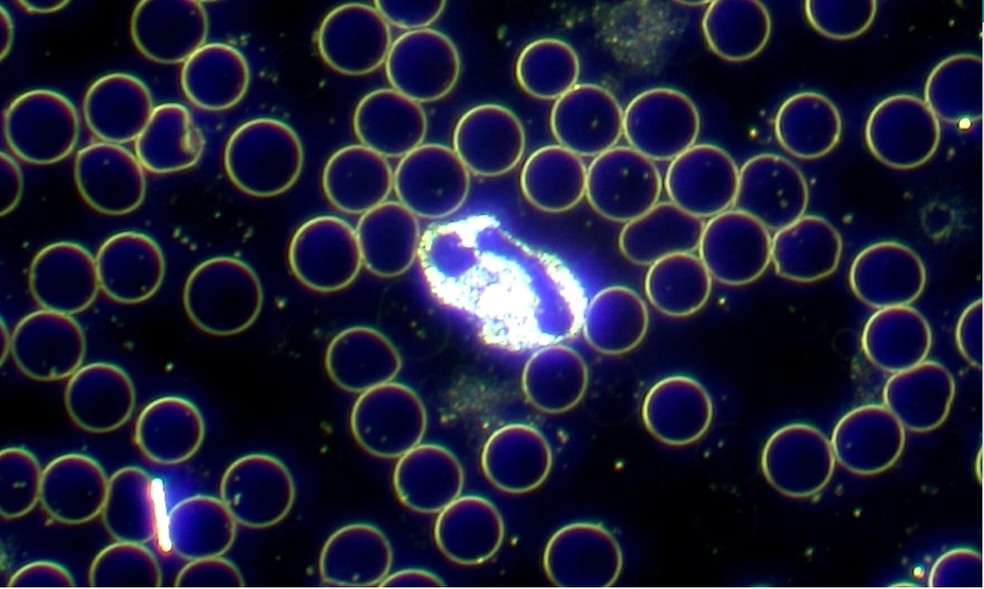

Diretor da Sociedade Brasileira de Patologia e médica hematologista afirmam que alegações contidas em vídeo viral são totalmente falsas e sem fundamento.
Circula nas redes sociais um vídeo em que um homem vestido de branco mostra uma tela e diz que a imagem mostra a presença de plástico no sangue de uma pessoa que tomou a segunda dose da vacina contra a Covid-19. É #FAKE.
No vídeo, o homem diz que se trata de uma microscopia de campo escuro. Ele exibe um ponto branco que diz ser plástico e uma outra estrutura que “parece uma espiral de DNA”, segundo ele.
De acordo com o vice-presidente de assuntos profissionais da Sociedade Brasileira de Patologia, Emílio Assis, e à médica hematologista do Hospital Sírio-Libanês e professora doutora Martha Mariana Arruda, as alegações contidas no vídeo são totalmente falsas. “O vídeo é fake. Não sei lhe dizer o que ele está vendo na tela, mas o que ele fala não tem base nenhuma”, diz Assis.
“Ele simplesmente não está mostrando nada. Se ele colocar um chumacinho de algodão na lâmina, aparece daquele jeito lá os tais ‘glóbulos brancos empilhados'”, diz a médica. Ela também rechaça a alegação do homem sobre a presença de plástico. “Plástico no sangue é incompatível com a vida”, diz.
Para exemplificar o quanto a imagem usada na mensagem falsa é falha e distante da realidade, Martha Mariana mostra uma foto com definição clara em que se pode enxergar um neutrófilo (um verdadeiro glóbulo branco) e hemácias (as bolinhas pretas que só têm a membrana marcada).
Martha Mariana diz também que a microscopia de campo escuro não é uma ferramenta eficaz para análises de “sangue vivo”, com o objetivo de detecção de doenças e, por isso, não é utilizada pela medicina sancionada pela comunidade científica.












